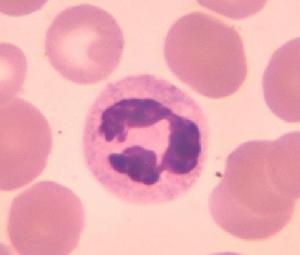
眼擬組織胞質菌病綜合徵

病因
 眼擬組織胞質菌病理圖
眼擬組織胞質菌病理圖POHS推測與組織胞質菌感染有關,這種推測基於患者均在或曾在美國俄亥俄州和密西西比河流域居住以及組織胞質菌素皮膚試驗陽性。但至今在POHS患者的典型病灶中仍無法分離出病原體,也未能培養出組織胞質菌。組織病理學的檢查主要是視網膜下的纖維及血管增生。發病機制是組織胞質菌在全身感染的同時脈絡膜發生了局部感染局部的炎症消退後即形成萎縮斑。變態反應或其他因素可促進萎縮斑處產生CNV,破壞Bruch膜長入視網膜下,最後形成盤狀纖維血管瘢痕。另外,感染也可影響色素上皮和脈絡膜毛細血管,導致漿液性或出血性視網膜脫離,最終也可形成纖維瘢痕。
發病機制:
眼擬組織胞質菌病綜合徵可經由呼吸道、皮膚、黏膜及胃腸鏡傳入流行區患者及感染動物的糞便等排泄物均可帶菌。當病原菌侵入人體後,視患者抵抗力情況可表現為原發或播散性感染。患者以男性為多,兒童患者易發展為進行性實驗室工作人員也可被感染。組織胞質菌侵入眼內後首先進入脈絡膜內,然後再侵及視網膜外層組織玻璃體內一般無炎性反應病理學主要特點為結節性肉芽腫性脈絡膜炎,可能為病原菌引起的一種局部組織過敏反應。黃斑部病變表現為Bruch膜破裂及新生血管形成,從而血液成分可滲漏到RPE下方或視網膜下或誘發視網膜下血管膜形成。此種出血性黃斑病變易於發生纖維化,形成盤狀瘢痕。病變晚期肉芽腫性炎症亦可侵及虹膜睫狀體。
臨床表現
 前房結構圖
前房結構圖診斷
臨床可根據POHS的眼底特點及陽性的組織胞質菌素皮膚試驗等對其進行診斷,但應注意與一些眼底出現白色斑點的其他疾病進行鑑別診斷。
鑑別診斷:
多灶性脈絡膜炎伴全葡萄膜炎的眼底表現與POHS極為相似但有明顯的前房和玻璃體的炎症表現常有生理盲點擴大多焦ERG檢查表現為持續的瀰漫性損害。鳥槍彈樣視網膜脈絡膜炎多見於老年人,為眼底多發性奶油色樣的病灶病灶無色素沉著但常伴有玻璃體炎症細胞浸潤。急性後極部多灶性鱗狀色素上皮病變也多見於年輕患者,可形成眼底萎縮斑但病灶較大且形態不規則,並主要位於後極部。急性期的病灶螢光素血管造影早期為遮蔽螢光,後期為強螢光。
檢查
中性粒細胞病理圖
中性粒細胞病理圖2.直接檢查 血、膿、痰、皮膚黏膜損害刮取物以及淋巴結、肝、脾骨髓等的抽吸物等製成塗片,以GMS或PAS染色,油鏡下可見2~4mm大小的卵圓形孢子,多存在於大單核細胞內。
3.真菌培養 莢膜組織胞質菌為雙相型真菌,標本接種於沙氏瓊脂室溫培養為真菌相菌落生長緩慢,呈白色棉花樣,鏡檢有菌絲和特殊形態的齒輪狀孢子具有傳染性。腦心浸膏血瓊脂37℃培養呈酵母相,有酵母樣菌落生長。鏡檢孢子直徑約1~5μm,卵圓形可出芽染色後很像洋蔥的切面。
4.組織病理學檢查 急性播散性患者的肺、肝、脾、骨髓和淋巴結中有大量組織細胞浸潤。細胞內外有大量的孢子非急性病例有上皮樣細胞肉芽腫形成。中性粒細胞、淋巴細胞、漿細胞、巨噬細胞和Langerhans巨細胞內也可含有孢子,但數目較少,大小也不一。陳舊損害中大多有組織腦漿菌瘤內有少量病原菌,周圍有纖維化。HE染色見細胞內孢子呈球形,略嗜鹼性,外圍的暈環為染色時退縮所致而並非真正的莢膜PSA和GMS染色清楚,呈現圓形或卵圓形酵母樣孢子,2~5μm直徑。可能有單芽,芽頸細,周圍無暈環。
其它輔助檢查:
眼底螢光素血管造影檢查:僅針對引起視覺症狀的CNV。造影早期可見新生血管的形態。組織胞質菌斑根據其色素的改變表現為邊界清晰的車輪狀的強螢光斑或遮蔽螢光。吲哚青綠血管造影在後極部可出現多發性的強螢光斑。
治療
 視盤
視盤原發感染的組織胞漿菌病,甚至是較嚴重者,只要臥床休息,加強營養等支持療法,即可逐漸痊癒。對於播散性病變、慢性空洞性病變、皮膚黏膜或系統性感染者則應進行抗真菌藥物治療首選藥物是兩性黴素B,對原發性病例,其總量應達0.5g,對慢性病例應達1~2g對波及腦部的少見病例,可考慮鞘內注射。對心內膜炎患者,總量1~2g仍顯不足,此時應與手術結合治療。咪康唑、酮康唑及氟康唑等可口服治療,副作用比兩性黴素B小。當經藥物治療臨床症狀停止發展後,對大的肺部空洞及肉芽性損害可考慮手術切除。為了防止手術時病變加劇或播散,可預防性地運用兩性黴素B。
預後:早期處理CNV可望保存有用視力。
預防:本菌的菌絲型感染性較強,實驗室工作者應注意預防在鳥籠雞窩等處常有本菌污染,應注意預防初到流行區的人,由於機體免疫力差,應特別注意 。
